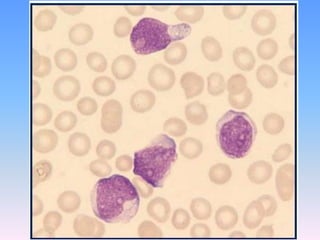

Acute myeloid leukemia (AML) is a cancer of the blood and bone marrow characterized by the rapid growth of abnormal white blood cells that build up in the bone marrow and blood. This document discusses the etiology, pathophysiology, clinical presentation, diagnosis, classification, and treatment of AML. It covers the French-American-British classification system and the newer World Health Organization classification system for AML subtypes. The WHO system categorizes AML based on recurrent genetic abnormalities, multilineage dysplasia with prior myelodysplastic syndrome, therapy-related AML, and other subtypes classified by morphology and cytochemistry.

![Allo BMT vs Auto BMT in Patients With
Ph- ALL: 5-Year Results
MRC/UK-ALL
• Improved OS with allo BMT vs auto BMT or postinduction
chemotherapy in standard-risk Ph- patients
– 5-year OS for allo BMT vs chemotherapy only: 54% vs 44%, respectively (P < .02)
– No advantage in high-risk patients ( older patients, WBC > 30,000 [B cell] or >
100,000 [T cell])
Outcome by Risk Group, % Donor
(n = 389)
No Donor
(n = 530)
P Value
Overall 5-yr survival 53 45 .02
High risk 40 36 .50
Standard risk 63 51 .01
10-yr relapse rate
High risk 39 62 < .0001
Standard risk 27 50 < .0001
Rowe JM, et al. ASH 2006. Abstract 2.](https://image.slidesharecdn.com/acuteleukemiacomplt-161017163342/85/Acute-leukemia-100-320.jpg)









![Clofarabine in ALL
• Approved in relapsed or refractory Pediatric ALL
• Children (N = 61)[1]; median of 3 prior regimens
– 52 mg/m2 on Days 1-5
• CR + CRp in 12 patients (20%); PR in 6 patients (10%)
• Median survival:13 weeks
• 9 responders proceeded to SCT
• Adults (N = 12)[2]
– Dose 40 mg/m2 on Days 1-5
– CR in 2 patients (17%)
• Toxicity : hepatotoxicity, palmarplantar erythrodysesthesia, druf
fever, rash 1. Jeha S, et al. J Clin Oncol. 2006;24:1917-1923.
2. Kantarjian H, et al. Blood. 2003;102:2379-2386.](https://image.slidesharecdn.com/acuteleukemiacomplt-161017163342/85/Acute-leukemia-110-320.jpg)
